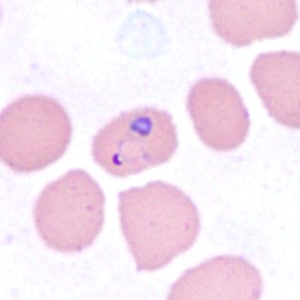
December - 2014 - Case #385

2014 DPDx Case Studies
DPDx Case Studies – 2014
December 2014

For the last Monthly Case Study for 2014, the DPDx Team thought we would fill your holiday stockings with a plethora of parasites! The following images were taken from a trichrome-stained stool specimen collected from a Haitian refugee. The original report documented several intestinal protozoa. How many can you identify?
November 2014
October 2014
September 2014
August 2014
July 2014
June 2014
May 2014
April 2014
March 2014
February 2014
January 2014
DPDx is an educational resource designed for health professionals and laboratory scientists. For an overview including prevention, control, and treatment visit www.cdc.gov/parasites/.